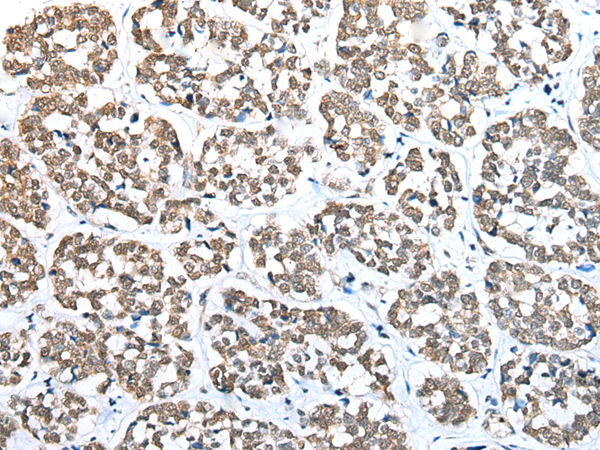
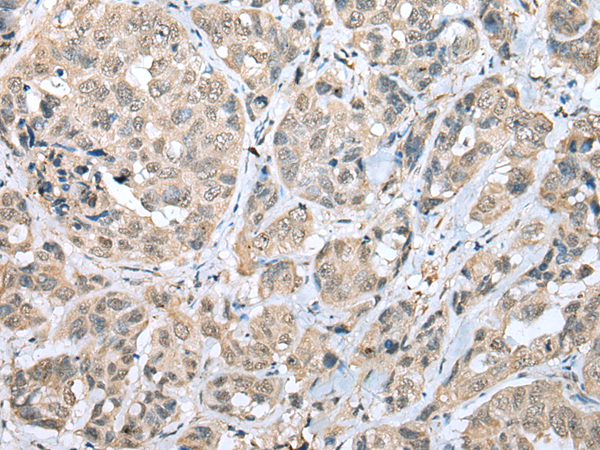
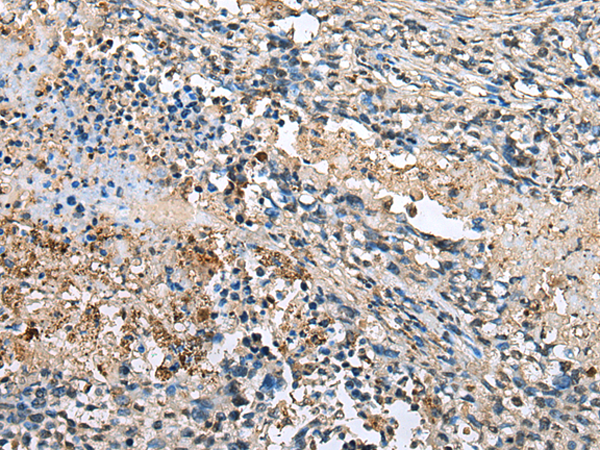
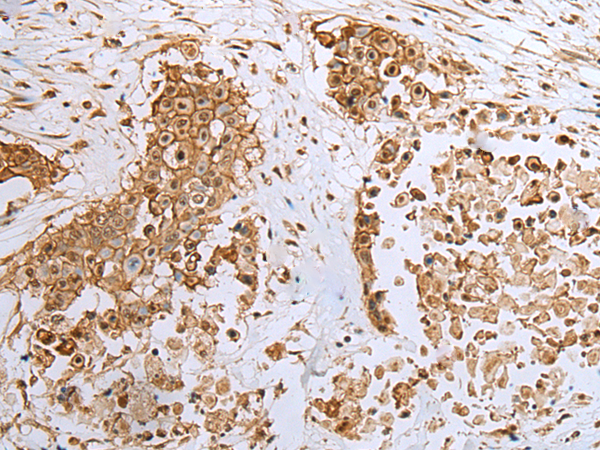
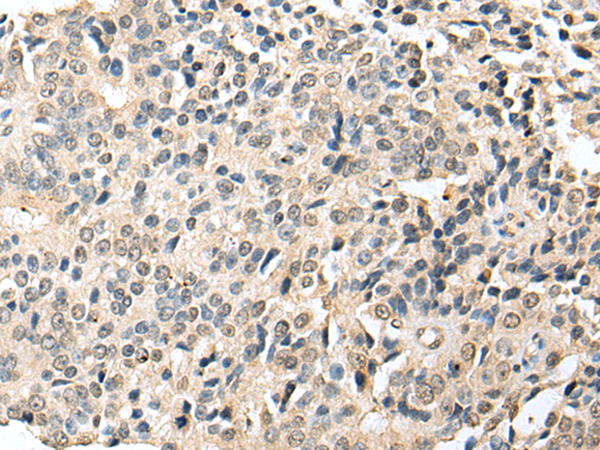

-
分类: 科研抗体货号: P09053别名: MPYCD; BRP44L; CGI-129; dJ68L15.3应用: WB,IHC反应种属: Human, Mouse, Rat
-
分类: 科研抗体货号: P09052别名: IFLTD1; PAS1C1应用: WB,IHC反应种属: Human
-
分类: 科研抗体货号: P09070别名: TGR; MAT-II; SDR23E1; MATIIbeta; Nbla02999应用: WB反应种属: Human, Mouse, Rat
-
分类: 科研抗体货号: P09051别名: AAG13; S100F; DT1P1A7应用: WB,IHC反应种属: Human
-
分类: 科研抗体货号: P09087别名: SLC35E2应用: IHC反应种属: Human
-
分类: 科研抗体货号: P09069别名: FXNA; KIAA1815; bA207C16.3应用: IHC反应种属: Human, Mouse, Rat
-
分类: 科研抗体货号: P09047别名: XR; DCR; HCR2; P34H; HCRII; KIDCR; PNTSU; SDR20C1应用: WB,IHC反应种属: Human, Mouse, Rat
-
分类: 科研抗体货号: P09086别名: CDH29; PRO34300应用: WB,IHC反应种属: Human, Mouse
-
分类: 科研抗体货号: P09068别名: CGI-134; S18mt-c; MRPS18-1; mrps18-c; MRP-S18-1; MRP-S18-c应用: WB,IHC反应种属: Human, Mouse
-
分类: 科研抗体货号: P09046别名:应用: IHC反应种属: Human

鄂公网安备42018502007531号
鄂公网安备42018502007531号

